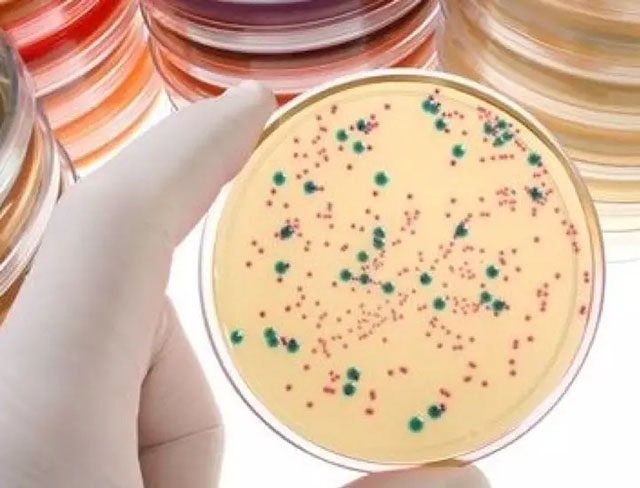

阴道微生物检测形态学金标准重新定义 双重荧光染色技术荣耀面世
- 分类:新闻中心
- 作者:
- 来源:
- 发布时间:2020-11-06
- 访问量:0
【概要描述】阴道分泌物中的上皮细胞、白细胞、线索细胞、球菌、杆菌、霉菌以及滴虫可以较好的反应阴道微生态环境,通过染色方法对以上指标进行观察评价可以辅助医生进行诊断。
阴道微生物检测形态学金标准重新定义 双重荧光染色技术荣耀面世
【概要描述】阴道分泌物中的上皮细胞、白细胞、线索细胞、球菌、杆菌、霉菌以及滴虫可以较好的反应阴道微生态环境,通过染色方法对以上指标进行观察评价可以辅助医生进行诊断。
- 分类:新闻中心
- 作者:
- 来源:
- 发布时间:2020-11-06
- 访问量:0

阴道分泌物中的上皮细胞、白细胞、线索细胞、球菌、杆菌、霉菌以及滴虫可以较好的反应阴道微生态环境,通过染色方法对以上指标进行观察评价可以辅助医生进行诊断。
传统的检验方法包括:湿片镜检法、格兰染色、酶化学法、培养法、分子诊断、免疫荧光等多种方法。
阴道微生物诊断检测方法对比


湿片镜检法
· 容易受到油滴水滴气泡影响的干扰,易漏诊
· 需要有经验的专业形态学人员的支持,人为影响较大

格兰染色
· 检测时间长(5-15min)
· 需要四步,操作复杂
· 不属于特殊染色,收费低,但成本高

酶化学法
· 酶的干扰因素多
· 无国际权威报道支持
· 临床符合率低
· 无法区分混合感染
· 只能初筛不能确证
· 操作复杂,需要45分钟
· 37度温育、冷链运输
培养法
· 耗时长(2-3天)
· 操作步骤多
· 设备要求高(各种不同培养箱)
· 外部影响因素多,容易污染

分子诊断
· 投入大、价格贵
· 流程复杂,有可能需要送第三方检测
· 时间长(2-3天)

免疫荧光
· 每个项目单独收费,费用昂贵;耗时长;操作复杂
· 不能同时看到多种病变,单样本要做多个涂片,会受到图片是样本不均一影响

美克独家首创的阴道微生物双重荧光染色液,具有荧光染色自动化,操作简便易判读,同一视野全标记,立等可取读报告的特点,成功克服了以上所有缺点,改写阴道微生物形态学检测金标准。

病原微生物同时标记

无需手动
染色过程一步完成
染色效果实拍欣赏

扫二维码用手机看
- COVID-19 Solutions
- 售后服务
- 咨询电话 025-58601060
- 返回顶部
微信公众号








